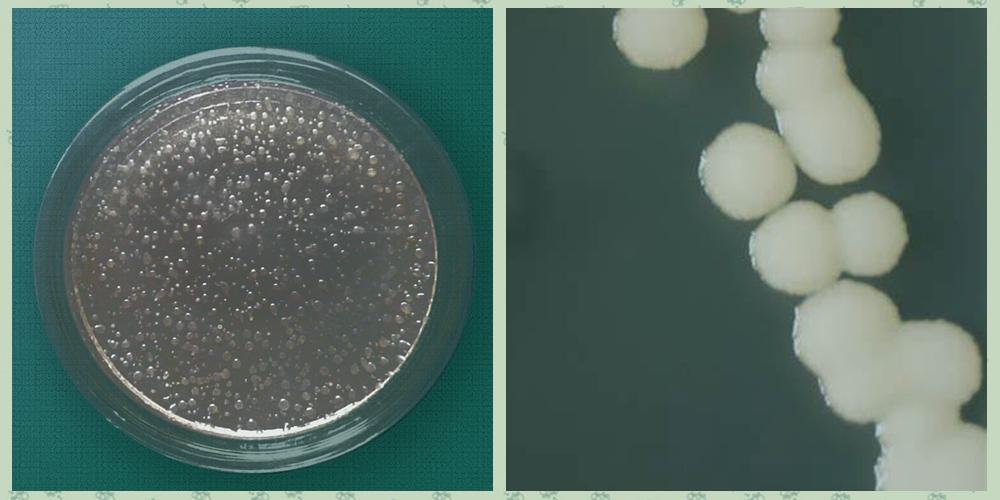
专业分析胶冻样类芽孢杆菌的来龙去脉

胶冻样

**胶冻样芽孢杆菌,胶冻样芽孢杆菌
图片尺寸640x320
和图片因保护患者隐私已被医生屏蔽我说的没错,是凝固,也就是胶冻状
图片尺寸576x1024
鼻炎 胶冻状痰
图片尺寸744x992
一.胶冻样类芽孢杆菌
图片尺寸934x707
山东胶冻样芽孢杆菌价格,胶冻样芽孢杆菌
图片尺寸640x320
孕39周1天2016-04-20 推荐回答 有一样的情况哦
图片尺寸400x400
心包积液(胶冻样物).
图片尺寸540x720
专业分析胶冻样类芽孢杆菌的来龙去脉
图片尺寸1000x500
严重冻伤一例
图片尺寸1024x768
预产期都过了11天,刚刚上厕所发现有果冻状,是怎么回事呢,是快生了吗?
图片尺寸400x400
请问西红柿炒鸡蛋的汤汁里面怎么会有胶冻样物质呢?
图片尺寸612x816
枯草芽孢杆菌_胶冻样芽孢杆菌_地衣芽孢杆菌_腐熟剂_哈茨木霉--瑞谷
图片尺寸450x600
官方胶冻样芽孢杆菌有口皆碑山东得和明兴贸易供应
图片尺寸640x320
冻胶样白色纤维长到呼吸道内(图)
图片尺寸1181x886
3例枸橼酸抗凝离心后血浆胶冻状,原因不明,欢迎讨论
图片尺寸1080x1440
包邮50亿1克胶冻样芽孢杆菌胶质芽孢杆菌厂家直销有机肥解磷解钾
图片尺寸390x400
市民买虾发现胶状物不敢吃
图片尺寸300x361
胶冻样类芽孢杆菌
图片尺寸847x829
胶冻样芽孢杆菌100亿全水溶 胶质芽孢杆菌 硅酸盐细菌
图片尺寸750x750
一例因达比加群引起的血清胶冻样标本处理分享
图片尺寸660x880